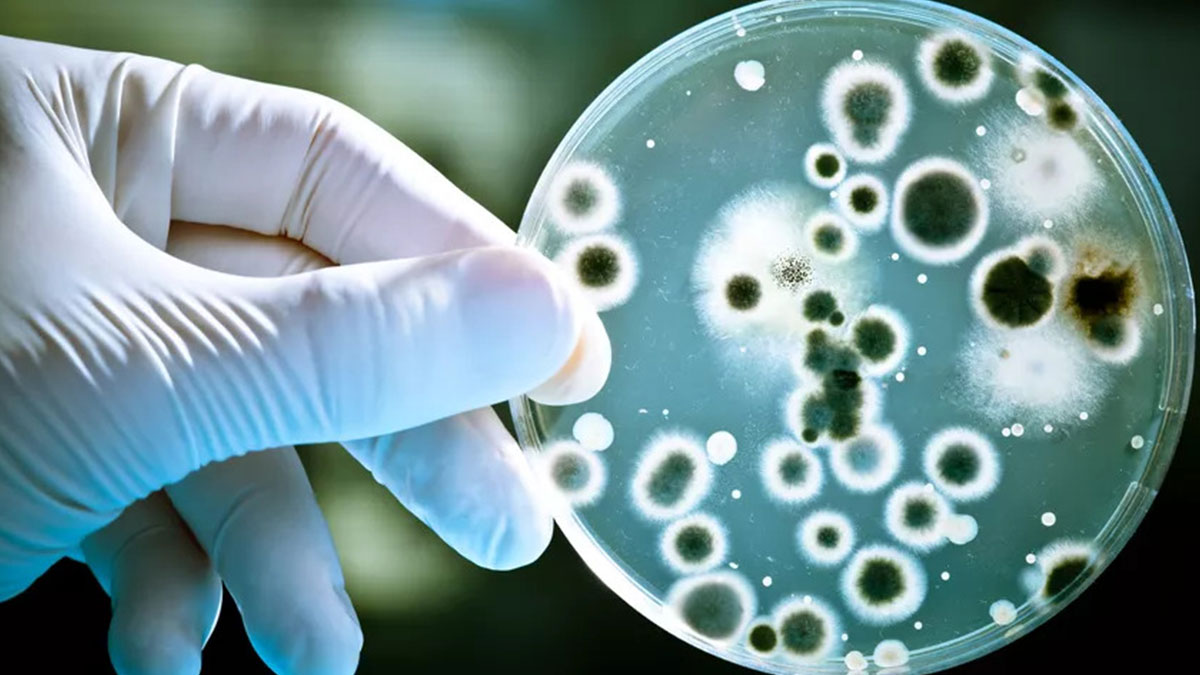
Bakteriler, çevresel değişimleri önceden sezerek evrim geçiriyor! Deneyimlerini de 'çocuklarına' aktarıyor

Bitki ve hayvanların, günlerin uzunluğuna bakarak yaşanacak çevresel değişiklikleri fark edebildiği uzun zamandır biliniyor.
Karmaşık organizmalar, fotoperiyodizm denen bu özellik sayesinde, örneğin günlerin kısalmasından yola çıkarak kışın geldiğini anlayıp buna göre hazırlık yapıyor.
Ancak bakterilerde böyle bir beceri bugüne kadar gözlemlenmemişti.
Hakemli dergi Science'ta 5 Eylül 2024'te yayımlanan çalışmayı yürüten ekip, mavi-yeşil alg diye de bilinen siyanobakteriler üzerinde bir dizi deney yaptı.
BAKTERİLERİN HAYATTA KALMA ORANLARI İNCELENDİ
Independent Türkçe'de yer alan habere göre, araştırmacılar, Synechococcus elongatus türündeki bir grup bakteriyi, yapay bir ortamda farklı sürelerde ışığa maruz bıraktı.
Bu sayede bazıları uzun, bazıları kısa, bazıları da gece-gündüz uzunluğunun eşit olduğunu günler deneyimledi. Ardından bakterileri iki saat boyunca buza koyan ekip, hayatta kalma oranlarını takip etti.
8 saat aydınlık, 16 saat karanlığa maruz bırakılarak kısa günler yaşatılan bakterilerin hayatta kalma oranı yüzde 75 olarak kaydedildi. Bu oran diğer grupların yaklaşık üç katıydı.
Bilim insanları bakterilerin kendini soğuğa hazırlaması için bir günün yeterli olmadığını da gözlemledi. Bakterilerin hayatta kalma oranı 6 ila 8 kısa günün ardından kayda değer derecede artıyordu.
Araştırmacılar ayrıca bakterilerin biyolojik saatini düzenleyen genleri devre dışı bırakarak aynı deneyi yürüttü. Bu durumda, bakterilerin önceden maruz kaldığı gün uzunlukları hayatta kalma oranları üzerinde bir fark yaratmadı.
BAKTERİLER DENEYİMLERİNİ 'ÇOCUKLARINA' AKTARIYOR
Makalenin başyazarı Dr. Luísa Jabbur bulguları şöyle açıklıyor:
"Doğadaki bakterilerin, biyolojik saatlerini kullanarak gün uzunluğunu ölçtüğünü ve kısa gün sayısı sonbahardaki gibi belirli bir noktaya ulaştığında, yaklaşan kışın zorluklarına karşı farklı bir fizyolojiye 'geçtiğini' görüyoruz."
Daha önceki çalışmalarda bakterilerin gece-gündüz uzunluklarını takip etmelerini sağlayan bir tür biyolojik saate sahip olduğu bulunmuştu. Ancak bu saatin, mevsimleri öngörüp hazırlık yapmaya yaradığı ilk kez kaydediliyor.
Ekip ayrıca bakterilerin bu bilgileri 'çocuklarına' da aktardığını tahmin ediyor ancak bunu nasıl yaptıklarını anlamak için daha fazla çalışmaya ihtiyaç var.
Fotosentez yaparak yaşayan siyanobakteriler, en az 2 milyar yıldır varlığını sürdürüyor. Dr. Luísa Jabbur, bu kadar eski ve basit bir organizmanın fotoperiyodizme sahip olmasından dolayı, bu özelliğin sanılandan çok daha önce evrimleştiğini düşünüyor.
ÇOK ERKEN DÖNEMDE ERİMLEŞEN STRES TEPKİ YOLLARINA İŞARET EDİYOR
Araştırmacılar ayrıca fotoperiyodizmin, aşırı ışık ve sıcağın yarattığı stresle başa çıkmak için mevcut mekanizmalar yardımıyla evrimleşmiş olabileceği görüşünde.
Makalenin bir diğer yazarı Prof. Carl Johnson da bulguların, sirkadiyen ritmin evrimi hakkında fikir verdiğini düşünüyor.
Uyku düzeni ve hormon üretimi gibi süreçleri düzenleyen sirkadiyen ritim, 24 saatlik döngü içinde metabolizmanın işleyişini düzenleyen bir biyolojik saat.
Prof. Carl Johnson şu ifadeleri kullanıyor:
"Fotoperiyodizmin bu kadar eski ve basit organizmalarda evrimleşmesi ve gen ifadesi sonuçlarımızın, muhtemelen Dünya'daki yaşamın çok erken dönemlerinde evrimleşen stres tepki yollarına işaret etmesi, bu özelliğin sirkadiyen saatlerden önce evrimleştiğini düşündürüyor."